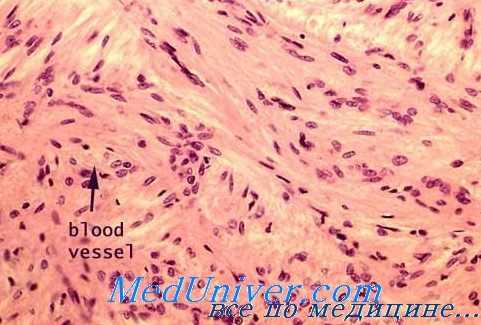
морфология гипоталамуса

Реакция гипоталамуса на гипоксию. Морфология ядер гипоталамуса при кислородном голодании
Добавил пользователь Дмитрий К. Обновлено: 20.11.2025
Реакция гипоталамуса на гипоксию. Морфология ядер гипоталамуса при кислородном голодании
Р. Т. Бойко изучала реакцию гомориположительных ядер среднего гипоталамуса на острую (4—6-часовая экспозиция в барокамере при остаточном давлении 160—180 мм рт. ст.) и хроническую прерывистую (ежедневное 5—6-часовое содержание в барокамере при остаточном давлении 350—360 мм рт. ст. па протяжении 8, 14 и 30 суток) гипоксию у кроликов на ранних этапах онтогенеза. Автор отмечает, что при острой гипоксии увеличивается содержание нейросекрета в нейронах супраоптического и паравентрикулярного ядер, что, вероятно, следует рассматривать как признак, указывающий па подавление секреторной активности. Хроническая гипоксия задерживала развитие гипоталамических нейросекреторных ядер и сопровождалась гибелью части нейронов.
В опытах Л. Е. Лузан, проводившихся в лаборатории Б. В. Алешина, было обнаружено, что в ответ на массивное кровопускание (вариант гемической гипоксии) у кроликов происходит значительная активация клеток супраоптического ядра. Если животным вводился физиологический раствор, количество которого соответствовало объему извлеченной крови, то реакция со стороны супраоптического ядра отсутствовала. Таким образом, но гипоксия, сопутствующая кровопотере, а связанная с ней дегидратация явилась причиной повышенной функции нейронов.
Аналогичный характер изменений со стороны нейросекреторных ядер переднего гипоталамуса у лиц, умерших от острой кровопотери, наблюдал Б. В. Антипов. Автор отмечает преобладание в «секреторной формуле» ядер гипоталамуса нейронов с морфологическими и цитохимическими признаками, типичными для фаз синтеза и гиперсекреции, при невысоком содержании клеток, находившихся на других фазах секреторного цикла. Этому соответствовало умеренное количество нейросекреторных веществ по ходу гипоталамо-нейрогипофизарного тракта и понижение содержания их в задней доле гипофиза.
Нейросекрет был представлен пылевидной и мелкозернистой (до 0.7 мкм) слабо окрашенной субстанцией с низкой оптической плотностью. По мнению автора, активация функции гипоталамо-нейрогипофизарной системы при острой кровопотере, по-видимому, направлена на развитие защитной вазоконстрикторной реакции периферического сосудистого русла.

Однако при дальнейшем изучении препаратов и применении морфометрических методов исследования было найдено, что статистически значимые сдвиги в сторону усиления функции нейронов супраоптического ядра в группе животных, которыо подвергались 5-часовым гипоксичоским воздействиям, отсутствуют.
В последующем нами было предпринято повторное исследование гипоталамо - нейрогипофизарной системы с более продолжительным гипоксическим воздействием.
Опыты были поставлены на 50 крысах-самцах весом 150—180 г. 20 из них составили контроль, остальные были разделены па 6 групп — по 5 крыс в каждой. Животные первой подопытной группы были забиты после содержания их в барокамере около 15 мин. па высоте 8000 м (острейшая гипоксия). Последующие группы забивались после 1, 2, 3, 5 и 10 ежедневных подъемов на ту же высоту (экспозиция 5 час). Морфологические и морфометрические исследования производились на срезах, окрашенных паральдегидфуксином по Гомори—Габу с докраской азаном по Гейденгайну.
При дифференцировании клеток, составляющих супраоптическое и паравентрикуляриоо ядра, мы использовали схему, предложенную З. Д. Кнорре с соавторами. По этой схеме выделяются 3 основных типа нейросекреторных клеток. Клетки I типа (наиболее крупные) характеризуются высокой активностью синтеза нейросекрета, однако темпы его выведения неодинаковы.
В соответствии с этим различают: клетки 1а типа, наиболее активно выводящие нейросекрет и потому практике ски лишенные его, клетки 1б типа с умеренным темпом выведения нейросокрета и потому содержащих его гранулы в небольшом количестве в перинуклеарной зоне, клетки 1в типа с пониженной активностью выведения нейросскрета и цитоплазмой, переполненной гомориположительными гранулами. Что касается клеток II типа, то они меньше размером, часто имеют вытянутую форму, со значительным количеством нейросекреторного вещества в цитоплазме; полагают, что эта картина отражает состояние пониженной активности как синтеза, так и выведения нейросекрета. И, наконец, к III типу относят дегенеративные («пикноморфные») нейросекреторные элементы.
В норме у крыс преобладают клетки Iа типа; это касается и супраоптического и паравентрикулярного ядра, где число этих клеток одинаково (табл. III и IV). Клетки 16 типа содержатся в большем количестве в паравентрикулярных ядрах. В супраоптических ядрах 6% клеток приходится на «дегенеративные» формы, что, по всей вероятности, представляет артефакт, неизбежно возникающий ввиду травмирования мозга при извлечении его из черепа; в паравентрикулярном ядре, расположенном в более глубоких отделах мозга, такие клетки встречаются редко. У обследованных нами крыс клеток Iв типа практически не было.
Таким образом, у интактных крыс имеется довольно высокая активность нейросекреторных ядер. Наши данные согласуются в этом отношении с результатами исследований других авторов (Кнорре и др., Иванова).
Таким образом, под влиянием кислородного голодания происходит кратковременная перестройка клеточной формулы супраоптического и паравентрикулярного ядер. На первых этапах гипоксичсского воздействия число нейронов с морфологическими признаками повышенного синтеза и выведения нейросекрета уменьшается. Соответственно увеличивается число клеток, менее активных в смысле экструзии нейросекреторных гранул.
Другими словами, организм крысы на первые встречи с гипоксическим стрессором отвечает некоторым снижением активности нейросекреторных ядер. К 3—5-му дню опыта клеточная формула практически не отличалась от нормальной, а у крыс, забитых на 10-е сутки, можпо было отметить слабо выраженную тенденцию к повышению функциональной активности обоих ядер. Реакции со стороны супраоптического и паравентрикулярного ядер происходят синхронно и выражены приблизительно с одинаковой степенью интенсивности.
Функции гипофиза при гипоксии. Масса аденогипофиза при кислородном голодании
Рассмотрение роли железистой части гипофиза в реакциях организма на кислородное голодание отдельно в известной мере искусственно. У 4 из 6 секретируемых передней долей гипофиза гормонов (адренокортикотропного — АКТГ, фолликулостимулирующего — ФСГ, или сперматогенезстимулирующего — ССГ, лютеинизирующего — ЛГ, или стимулирующего интерстициалыше клетки — ИКСГ, и тиреотропного — ТТГ) точкой приложения являются периферические эндокринные железы. Специфические эффекты лактотропного (ЛТГ) гормона хотя и не ограничиваются стимуляцией молокообразования, также реализуются преимущественно через изменения специализированных железистых элементов на периферии.
Даже такой гормон «общего действия», как соматотропный (СТГ), оказывает влияние на структуру и функцию инсулярного аппарата поджелудочной железы. После многократных инъекций СТГ В-клетки подвергаются деструктивным изменениям, а клинически регистрируются явления, характерные для диабета, которые, правда, отчасти зависят также от мобилизации гликогена из печени (Houssay, Rietti).
Мы сочли возможным рассмотреть аденогипофиз отдельно не только из-за удобства изложения материала по органному принципу, т. е. по железам, но также из тех соображений, что физиологическая роль передней доли, конечно, но исчерпывается только кринотропными эффектами, а проявляется и многосторонними влияниями на межуточный обмен. Это казалось целесообразным еще и потому, что аденогипофиз, несмотря на многообразие выполняемых им функций, представляет собой единое в анатомо-физиологическом отношении образование. Особое положение аденогипофиза в системе эндокринных желез обусловило то, что о его состоянии при гипоксии чаще судят по сдвигам в железах, которые находятся под контролем тройных гормонов.
Мы попытались дать гистофизиологическую характеристику тем изменениям, которые происходят в аденогипофизе при длительной прерывистой гипоксической гипоксии. По существу, этот вопрос не изучен. Только в двух работах нам удалось найти сведения о том, что при гипоксической гипоксии и отравлении угарным газом в аденогипофизе происходит гиперплазия базофильных элементов и появляются клетки кастрации (Patterson et al., Gordon et al.).

Опыты были поставлены на 118 белых беспородных крысах-самцах со средним весом 180 ±30 г. Животные были разделены на 10 групп — одну контрольную (28 крыс) и 9 подопытных (от 8 до 11 животных в каждой группе). Гипоксия воспроизводилась в барокамере при разрежении 220 мм рт. ст. (9000 м) и экспозиции 5 час.
Животные первой группы были забиты отсечением головы после одного подъема. Последующие забои производились на 2-е, 3-й, 5-е, 10-е, 15-е и 25-е сутки после каждодневных 5-часовых сеансов. Гипофиз извлекался сразу после умерщвления крыс и во избежание деформации фиксировался в жидкости Буэна вместе с костной пластинкой турецкого седла; затем он отделялся от кости и заливался в парафин. Приготавливалось не менее 10 ступенчатых срезов из каждого блока толщиной от 5 до 7 мкм, проходивших в горизонтальной плоскости органа. Срезы окрашивались гематоксилин-эозином, азаном по Гейденгайну, иикрофуксином по Ван-Гизону, паральдегидфуксином по Гомори—Габу с докраской азаном и на гликопротеиды по МакМанусу—Хочкиссу.
Цито- и кариометрия производилась методом оптической проекции через рисовальный аппарат с последующим взвешиванием изображений. Результаты выражались в относительных единицах. Этот метод применительно к гипофизу предпочтительней, так как измерения с помощью окулярмикрометра из-за неправильной формы железистых клеток аденогипофиза дают вариационные ряды с большим разбросом.
У крыс контрольной группы вес гипофиза колебался в очень небольших пределах: у 6 животпых он составлял 5 мг, у 3 — 6 мг и лишь у одной крысы равнялся 4 мг. Незначительная вариабельность рядов имела место и в подопытных группах (коэффициент вариации 4.6—10.1%), исключая группу крыс, забитых на 16-е сутки, где коэффициент вариации был равен 42.4%.
После первого подъема средний вес гипофиза достоверно увеличился (на 12.3%). В последующие два срока он оставался повышенным, однако разница с контролем была несущественна. После 12 и 16 подъемов отмечено достоверное снижение веса гипофиза (максимум на 13.0% от контроля и на 16.0% от средней для первой подопытной группы). У крыс, забитых на 20-е и 24-е сутки, вес гипофиза не отличался от нормы.
Гипоталамическая нейросекреция. Эндокринная функция гипоталамуса
До последнего времени в центре внимания оставались так называемые крупноклеточные, гомориположительные парные ядра переднего гипоталамуса — супраоптическое и паравентрикулярное. Именно эти ядра, вместе с отростками составляющих их нейронов (супраоптико- и паравентрикуло-гипофизарный тракты) и задней долей гипофиза, и представляли в совокупности гипоталамо-птпофизарную нейросекроторную систему (ГГНС), которой приписывали многосторонние влияния на функции организма, а некоторые исследователи ставили чуть ли не знак равенства между ГГНС и гипоталамусом в целом.
По современным, еще не окончательно сложившимся представлениям, гомориположительные нейросекреторные ядра переднего гипоталамуса и относящиеся к ним структуры образуют лишь часть ГГНС, а имсппо — гипоталамо-псйрогипофизарную систему. В нейронах ее секретируются нейрогипофизарные гормоны — вазопрессин (или антидиуретический гормон — АДГ) и окситоцин.
Мелкоклеточные гомориотрицательные ядра аденогипофизотропной зоны среднего гипоталамуса (аркуатное, вентромедиарное и др.), аксоны: их нейронов (туберо-инфундибулярный тракт) и срединное возвышение формируют относительно автономную гипоталамо-аденогипофизарную систему (Flerco, Szentagothai, Сентаготаи и др.).
Полагают, что в нейронах аденогипофизотропной зоны секкретируются активирующие и ингибирующие выработку тропных гормонов передней доли гипофиза хемомедиаторные вещества (releasing and inhibiting factors). Доказано существование факторов, стимулирующих секрецию соматотропного, тиреотроппого, адренокортикотропного, фолликулостимулирующего, лютеинизирующего и меланоцитостимулирующего гормонов.

В вытяжках из гипоталамуса пайдены также соединения, угнетающие секрецию соматотропного, лактотропного и меланоцитостимулирующего гормонов (Алешин).
Аденогипофизотропные гипоталамические факторы лишь усиливают или ослабляют продукцию соответствующих аденогипофизарных гормонов и не являются пусковыми агентами, — секреция может происходить и в их отсутствие (Алешин). Наиболее зависимы от гипоталамической регуляции гонадотропные гормоны (Benojt, Assenmacher, Harris). Тиреотропный, соматотропный и адренокортикотропный (последний особенно в условиях стресса) обнаруживают слабую (Shirley, Nalbantlov, Hertz, Florsheim, Knigge и др.), а лактотропный— отрицательную (Rothchild, Nikitovitch-Winer) зависимость.
В основе разделения ГГНС на нейро- и аденогипофизарный компоненты лежит большое число убедительных фактов, подробный анализ которых приводится в монографии Б. В. Алешина.
Следует, однако, иметь в виду, что в срединном возвышении заканчивается некоторая часть аксонов супраоптико-паравентрикуло-гипофизарного тракта. Поэтому там постоянно обнаруживается гомориположительпый нейросекрет и, разумеется, содержатся нейрогипофизарные гормоны (АДГ и оксигоцин). Проникновение их в кровь, омывающую клетки аденогипофиза, представляется не менее вероятным, чем проникновение хемомедиаторов из аденогипофизотропной зоны гипоталамуса. Возникает, таким образом, вопрос о возможном влиянии (прямом или опосредованном) нейрогормонов па аденогипофиз.
Б. В. Алешин полагает, что они могут участвовать в регуляции аденогипофизарного гормонопоэза совместно со специфическими активирующими веществами, действуя в качестве кофакторов по следних. По мнению А. Л. Поленова, нейрогормоны оказывают, кроме того, влияние на периферические эндокринные железы, минуя переднюю долю гипофиза, — парааденогипофизарно.
Супраоптическое и паравентрикулярное ядра переднего гипоталамуса, а точнее гипоталамо-нейрогипофизарная система, несомненно участвуют в различного рода стрессорных ситуациях, в том числе, как будет показано далее, и при гипоксических воздействиях. Изложенное выше заставляет с еще большей, чем ранее, осторожностью интерпретировать значение факта включения этой системы в реакцию напряжения.
Он уже не может рассматриваться как прямое доказательство возникновения в гипоталамусе при определенной ситуации очага гуморальной стимуляции (или ингибиции) аденогипофиза. Вместе с тем попытки установления корреляций между морфофункциональным состоянием гомориположительных ядер и функциями организма, регуляция которых осуществляется АДГ и окситоцином, были и остаются достаточно обоснованными.
Клеточный состав гипоталамуса. Влияние гипоксии на клетки супраоптического и паравентрикулярного ядер
Статистический анализ показал, что сама по себе клеточная формула не является в достаточной мере чувствительным показателем изменений нейросекреторпой активности. Во всяком случае, выводы, полученные на основании ее анализа, следует рассматривать как ориентировочные. В связи с этим мы попытались подойти к оценке морфофункционального состояния нейронов супраоптического п паравептрикулярного ядер, используя карио-метрию. Изображения ядер переносились с помощью рисовального аппарата на стандартную бумагу, затем вырезались и взвешивались.
Измерение ядер производилось у клеток двух типов, отличающихся не содержанием нейросекрета, как в ранее использованной схеме, а окраской цитоплазмы. К первому типу отнесены элементы со светлой нейроплазмой — «светлые» клетки. Большинство их у крысы представлено клетками Iа типа. Цитоплазма их оптически пуста, иногда вакуолизирована. Часть «светлых» клеток относится к элементам 16 типа, содержащих в перинуклеарной зоне умеренпое количество нейросекреторных гранул.
Ко второму типу отнесены «темные» клетки, цитоплазма которых окрашивается азаном по Гейденгайну в красный цвет; в цитоплазме может содержаться различное количество нейросекреторных гранул. Полагают, что «светлые» клетки более активны в функциональном отношении, чем «темные» (Ивапова).
Изменения размеров ядер, выраженные в условных единицах, в супраоптическом и паравентрикулярном ядрах в целом совпадают: уменьшение размеров в первые сутки в последующем сменяется их увеличением. Изменения в количестве «светлых» и «темных» клеток происходят сипхропно. Особенно это выражено в паравентрикулярпых ядрах. Вариационные ряды характеризуются небольшим разбросом — средние, отстоящие на 50 условных единиц по шкале ординат, обычно значимо отличаются друг от друга.
Данные кариометрических исследований подтверждают, таким образом, вывод, сделанпый на основании анализа формулы: на первых этапах прерывистой гипоксической гипоксии происходит угнетение функциональной активности супраоптического и паравентрикулярного ядер. Здесь более отчетливо выявилась тенденция к усилению активности на конечных этапах гипоксического воздействия.
Продуцируемый крупноклеточными ядрами переднего гипоталамуса гомориположительный нейросекрет распространяется по ходу аксонов, заканчивающихся в задней доле гипофиза. Нами обнаружен параллелизм в содержании нейросекреторного вещества в клетках и их отростках, составляющих гипоталамо-нейрогипофизарный тракт. У крыс с кратковременным гипоксическим воздействием и у однократно поднятых на высоту количество гомориположителыгого материала увеличивается. Именно в этих группах, как уже указывалось, отмечалось снижение числа клеток Iа типа, уменьшение диаметра ядер «светлых» и «темных» элементов и увеличение числа клеток 16 типа с замедленным оттоком нейросокрета. 2-, 3- и 5-кратные подъемы, во время которых происходила нормализация формулы и сдвиг в сторону усиления функционального напряжения (увеличение числа клеток Iа типа, диаметра ядер «светлых» и «темных» клеток), приводят также к снижению нейросекрета в клетках и отростках вплоть до полного его исчезновения у отдельных особей.
Учитывая незначительную чувствительность метода, вряд ли можно говорить о существенных изменениях в содержании гомориположителыгого материала в задней доле гипофиза.
Проведенное нами исследование показало, что гипоталамо-нейрогипофизарная система несомненно реагирует на прерывистую гипоксическую гипоксию. По всей видимости, эта реакция носит двухфазный характер. Животные, поставленные в условия дефицита кислорода, первоначально отвечают угнетением функционального состояния нейросекреторных ядер переднего гипоталамуса, что выражается в замедлении выведения нейросокрета в отростки и в продвижении его в дисталыюм направлении. Поскольку нейроны этих ядер продуцируют АДГ, можно считать весьма вероятным, что повышение диуреза, отмечаемое обычно при гипоксии, отчасти связано с дефицитом этого гормона.
Продолжающееся гипоксическое воздействие приводит вначале к активизации выведения нейросекрета, а затем к сдвигам в формуле и размерах ядер, указывающих па постепенное повышение функционального напряжения нейросекреторпой системы. Возможно, что это связано с наступившим в результате предшествующей полиурии обезвоживанием организма и необходимостью сохранения осмотически свободной воды.
Повышение диуреза на начальных этапах гипоксического воздействия, как уже указывалось, не совсем ясно. Возможно, что эта реакция, наблюдающаяся, как и многие другие, при умеренных степенях кислородного голодания, представляет собой явление приспособительного характера.
В связи с этим интересно было выяснить, произойдут ли изменения в устойчивости крыс к кислородному голоданию при искусственном повышении реабсорбции воды в почках. С этой целью 20 крысам-самцам весом 160—180 г за 30 мин. до подъема на высоту около 10 500 м подкожно в дозе 1 единица на 100 г веса был введен питуитрин II (водный экстракт задней доли гипофиза, консервированный 3%-м раствором фенола). 20 контрольным животным подкожно введено 0.3 мл 3%-го раствора карболовой кислоты. Крысы выдерживались на высоте 15 мин. Введение питуитрина П никакого влияния на устойчивость к острой гипоксической гипоксии не оказало: в подопытной и контрольной группах погибло одинаковое количество животных.
Из этого можно сделать вывод, что либо предполагаемый адаптивный эффект повышения диуреза при гипоксии не играет существенной роли в устойчивости, либо, возможно, введение препарата не оказывает значительного влияния на потерю воды, осуществляемую к тому же не только через почки.
Полученные в этом опыте результаты, на наш взгляд, не противоречат ранее установленному факту участия гипоталамо-нейрогипофизарпой системы в гипоксическом синдроме. Возвращаясь к нему, необходимо отметить, что механизмы первоначального подавления ядер переднего гипоталамуса при гипоксической гипоксии, а равно увеличение их активности при гемической (острая кровопотеря) и на последующих этапах гипоксической гипоксии в основном, по-видимому, связаны со сдвигами в водно-осмотическом равновесии организма.
Вопрос о возможной зависимости между нейросекрецией в супраоптическом и паравентрикулярном ядрах, с одной стороны, и сосудистым тонусом, с другой, требует специального изучения. Известно, что умеренные степени острой гипоксии пе сопровождаются изменениями артериального давления (Van Liere, Stickney). При тяжелой острой гипоксической гипоксии обычно регистрируется артериальная гипертензия, но, как это было уже давно показано, она не возникает после полной денервации сипокаротидного синуса и перерезки блуждающих нервов, так как имеет, вероятно, рефлекторную природу (Heymans et al., Gellhorn, Lambert). Сомнительно, чтобы АДГ, обладающий слабым вазоконстрикторным действием, принимал участие в ее формировании.
Гипоталамический синдром
Гипоталамический синдром – комплекс эндокринных, обменных, вегетативных расстройств, обусловленных патологией гипоталамуса. Характеризуется изменением (чаще увеличением) массы тела, головными болями, неустойчивостью настроения, гипертензией, нарушением менструального цикла, повышенным аппетитом и жаждой, усилением или снижением либидо. Для диагностики гипоталамического синдрома проводится расширенное гормональное исследование, ЭЭГ, МРТ головного мозга, при необходимости УЗИ щитовидной железы, надпочечников. Лечение гипоталамического синдрома заключается в подборе эффективной стимулирующей или ингибирующей гормональной терапии, проведении симптоматического лечения.
Общие сведения
Гипоталамический синдром – комплекс эндокринных, обменных, вегетативных расстройств, обусловленных патологией гипоталамуса. Характеризуется изменением (чаще увеличением) массы тела, головными болями, неустойчивостью настроения, гипертензией, нарушением менструального цикла, повышенным аппетитом и жаждой, усилением или снижением либидо. Прогноз зависит от тяжести поражения гипоталамуса: от возможности полного выздоровления до прогрессирования заболевания (развитие выраженного ожирения, стойкой гипертонии, бесплодия и т. д.).
Патология гипоталамической области часто встречается в эндокринологической, гинекологической, неврологической практике, вызывая сложности в диагностике из-за многообразия форм проявления. Гипоталамический синдром чаще развивается в подростковом (13-15 лет) и репродуктивном (31-40 лет) возрасте, преобладая у лиц женского пола (12,5–17,5% женщин).
Проблема медицинской и социальной значимости гипоталамического синдрома определяется молодым возрастом пациентов, быстро прогрессирующим течением заболевания, выраженными нейроэндокринными нарушениями, нередко сопровождающимися частичным снижением или полной утратой трудоспособности. Гипоталамический синдром вызывает серьезные нарушения репродуктивного здоровья женщины, вызывая развитие эндокринного бесплодия, поликистоза яичников, акушерские и перинатальные осложнения.
Причины развития гипоталамического синдрома
Гипоталамический отдел головного мозга отвечает за регуляцию гуморальных и нервных функций, обеспечивающих гомеостаз (стабильность внутренней среды). Гипоталамус выполняет роль высшего вегетативного центра, регулирующего обмен веществ, терморегуляцию, деятельность кровеносных сосудов и внутренних органов, пищевое, половое поведение, психические функции. Кроме того, гипоталамус управляет физиологическими реакциями, поэтому при его патологии нарушается периодичность тех или иных функций, что выражается вегетативным кризом (пароксизмом).
Вызывать нарушения деятельности гипоталамуса и развитие гипоталамического синдрома могут следующие причины:
- опухоли головного мозга, сдавливающие гипоталамическую область;
- черепно-мозговые травмы с прямым повреждением гипоталамуса;
- нейроинтоксикации (токсикомания, наркомания, алкоголизм, производственные вредности, экологическое неблагополучие и т. д.);
- сосудистые заболевания, инсульт, остеохондроз шейного отдела позвоночника;
- вирусные и бактериальные нейроинфекции (грипп, ревматизм, малярия, хронический тонзиллит и др.);
- психогенные факторы (стрессы, шоковые ситуации, умственные нагрузки);
- беременность и сопряженные с ней гормональные перестройки;
- хронические заболевания с вегетативными компонентами (бронхиальная астма, гипертония, язвы желудка и двенадцатиперстной кишки, ожирение);
- конституциональная недостаточность гипоталамической области.
Классификация гипоталамического синдрома
Клиническая эндокринология насчитывает большое число исследований по изучению гипоталамического синдрома. Результаты этих исследований легли в основу современной расширенной классификации синдрома.
По этиологическому принципу гипоталамический синдром подразделяется на первичный (вследствие нейроинфекций и травм), вторичный (вследствие конституционального ожирения) и смешанный.
По ведущим клиническим проявлениям выделяют следующие формы гипоталамического синдрома:
- вегетативно-сосудистую;
- нарушения терморегуляции;
- гипоталамическую (диэнцефальную) эпилепсию;
- нейротрофическую;
- нервно-мышечную;
- псевдоневрастеническую и психопатологическую;
- расстройство мотиваций и влечений;
- нейроэндокринно-обменные расстройства.
Выделяют клинические варианты гипоталамического синдрома с преобладанием конституционального ожирения, гиперкортицизма, нейроциркуляторных нарушений, герминативных расстройств.
Тяжесть проявления гипоталамического синдрома может быть легкой, средней и тяжелой формы, а характер развития – прогрессирующий, стабильный, регрессирующий и рецидивирующий. В пубертатном периоде гипоталамический синдром может протекать с задержкой или ускорением полового созревания.
Симптомы гипоталамического синдрома
Проявления гипоталамического синдрома зависят от зоны поражения гипоталамуса (передний или задний отделы) и вызванных нейрогуморальных расстройств в гипоталамо-гипофизарной области. В проявлениях гипоталамического синдрома чаще преобладают следующие нарушения:
- вегетативно-сосудистые – 32%,
- эндокринно-обменные – 27%,
- нервно-мышечные – 10%,
- нарушения терморегуляции и др. - 4% и т. д.
Гипоталамический синдром проявляется общей слабостью, повышенной утомляемостью, физическим и психическим истощением, плохой переносимостью смены метеорологических условий, покалываниями в сердце, склонностью к аллергическим реакциям, неустойчивым стулом, чувством нехватки воздуха, эмоциональными расстройствами (тревогой, приступами панического страха), нарушениями сна, повышенной потливостью. Объективно выявляются тахикардия, асимметрия артериального давления со склонностью к его повышению, тремор пальцев и век.
У большей части пациентов гипоталамический синдром протекает пароксизмально (приступообразно), чаще в виде вагоинсулярных и симпатико-адреналовых кризов. Вазоинсулярные кризы при гипоталамическом синдроме сопровождаются чувством жара, прилива к лицу и голове, головокружением, удушьем, неприятными ощущениями в эпигастрии, тошнотой, замиранием сердца, потливостью, общей слабостью. Может наблюдаться усиленная перистальтика кишечника с послаблением стула, учащенное и обильное мочеиспускание, повторные позывы в туалет. Возможно развитие аллергических проявлений в форме крапивницы и даже отека Квинке. Частота сердечных сокращений урежается до 45-50 уд. в мин., АД снижается до 90/60-80/50 мм рт. ст.
Продолжительность криза может быть от 15 мин. до 3 и более часов, после чего на протяжении нескольких часов сохраняется слабость и страх повторения подобного приступа. Часто при гипоталамическом синдроме кризы носят смешанный характер, сочетая симптомы вагоинсулярного и симпатико-адреналового кризов.
Нарушение терморегуляции при гипоталамическом синдроме сопровождается развитием гипертермического криза, характеризующегося внезапным скачком температуры тела до 39-40 °С на фоне длительного субфебрилита. Для терморегуляционных нарушений типично утреннее повышение температуры и ее снижение к вечеру, отсутствие эффекта от приема жаропонижающих препаратов. Расстройства терморегуляции чаще наблюдаются в детском и юношеском возрасте и зависят от физического и эмоционального напряжения. У подростков они нередко связаны со школьными занятиями и исчезают в каникулярный период.
Проявлениями терморегуляционных нарушений при гипоталамическом синдроме могут служить постоянная зябкость, непереносимость сквозняков и низких температур. Такие пациенты постоянно кутаются, носят одежду не по погоде, даже в теплое время не открывают форточки и окна, избегают принимать ванну. Расстройство мотиваций и влечений при гипоталамическом синдроме характеризуется эмоционально-личностными нарушениями, различными фобиями, изменением либидо, патологической сонливостью (гиперсомнией) или бессонницей, частой сменой настроения, раздражительностью, гневом, слезливостью и т. д.
Нейроэндокринно-обменные расстройства при гипоталамическом синдроме проявляются нарушением белкового, углеводного, жирового, водно-солевого обмена, булимией, анорексией, жаждой. Нейроэндокринные нарушения могут сопровождаться синдромами Иценко-Кушинга, несахарного диабета с полиурией, полидипсией и низкой относительной плотностью мочи, акромегалией, ранним климаксом у молодых женщин, изменениями в щитовидной железе. Могут наблюдаться дистрофия костей и мышц, нарушения трофики кожи (сухость, зуд, пролежни), изъязвления слизистых внутренних органов (пищевода, 12-перстной кишки, желудка). Для гипоталамического синдрома характерно хроническое или длительное течение с рецидивами и обострениями.
Осложнения гипоталамического синдрома
Течение гипоталамического синдрома наиболее часто осложняется поликистозными изменениями яичников, гинекомастией, нарушениями менструального цикла от олиго- и аменореи до маточных кровотечений, миокардиодистрофией, гирсутизмом и инсулинорезистентностью. Осложнением беременности при гипоталамическом синдроме может являться тяжелая форма позднего гестоза.
Диагностика гипоталамического синдрома
Полиморфная клиника гипоталамического синдрома представляет немалые трудности в его диагностике. Поэтому ведущими критериями диагностики гипоталамического синдрома служат данные специфических тестов: сахарной кривой, термометрии в трех точках, ЭЭГ головного мозга, трехдневной пробы Зимницкого.
Глюкозу крови при гипоталамическом синдроме исследуют натощак и с нагрузкой 100 г сахара, определяя уровень глюкозы через каждые 30 минут. При гипоталамическом синдроме встречаются следующие варианты сахарной кривой:
- гипергликемический (подъем уровня глюкозы выше нормы);
- гипогликемический (содержание глюкозы ниже нормы);
- двугорбовый (снижение уровня глюкозы чередуется с новым подъемом);
- торпидный (небольшой подъем глюкозы фиксируется в одной точке).
Термометрию при гипоталамическом синдроме проводят в трех точках: обеих подмышечных впадинах и в прямой кишке. Термометрические нарушения могут выражаться в изотермии (равной температуре в прямой кишке и подмышечных областях, при норме в прямой кишке на 0,5-1°С выше); гипо- и гипертермии (в подмышечных впадинах температура ниже или выше нормы); термоинверсии (температура в прямой кишке ниже, чем в подмышечных впадинах).
Электроэнцефалография выявляет изменения, затрагивающие глубинные структуры мозга. В трехдневной пробе по Зимницкому у пациентов с гипоталамическим синдромом изменяется соотношение выпитой и выделяемой жидкости, ночного и дневного диуреза. Методом МРТ головного мозга при гипоталамическом синдроме выявляется повышенное внутричерепное давление, последствия гипоксии и травм, опухолевые образования.
Обязательным критерием диагностики гипоталамического синдрома является определение гормонов (пролактина, ЛГ, эстрадиола, ФСГ, тестостерона, кортизола, ТТГ, Т4 (свободного тироксина), адренотропного гормона в крови и 17-кетостероидов в суточной моче) и биохимических показателей для выявления эндокринно-обменных нарушений. Дифференцировать гипоталамический синдром с органическим поражением других систем позволяет УЗИ надпочечников, УЗИ щитовидной железы и внутренних органов. При необходимости дополнительно проводится МРТ или КТ надпочечников.
Лечение гипоталамического синдрома
Комплекс мероприятий по лечению гипоталамического синдрома должен осуществляться совместными усилиями эндокринолога, невролога и гинеколога (у женщин). Подбор методов лечения гипоталамического синдрома всегда индивидуален и зависит от ведущих проявлений. Целью терапии гипоталамического синдрома является коррекция нарушений и нормализация функции гипоталамических структур головного мозга.
На первом этапе лечения проводят устранение этиологического фактора: санацию инфекционных очагов, лечение травм и опухолей и т. д. При интоксикациях алкоголем, наркотиками, инсектицидами, пестицидами, тяжелыми металлами проводится активная дезинтоксикационная терапия: внутривенно вводятся солевые растворы, тиосульфат натрия, глюкоза, физиологический раствор и др. Для профилактики симпатико-адреналовых кризов назначаются пирроксан, алкалоиды красавки + фенобарбитал, сульпирид, тофизопам, антидепрессанты (тианептин, амитриптилин, миансерин и др.).
Нейроэндокринные нарушения корректируются заместительными, стимулирующими или тормозящими гормональными препаратами, назначением диеты и регуляторов нейромедиаторного обмена (бромокриптин, фенитоин) курсом до полугода. При развитии посттравматического гипоталамического синдрома проводят дегидратирующую терапию, цереброспинальную пункцию. При нарушениях обмена назначается диетотерапия, анорексанты, витамины.
При гипоталамическом синдроме назначаются средства, улучшающие мозговое кровообращение (пирацетам, гидрализат головного мозга свиней, винпоцетин), витамины группы В, аминокислоты (глицин), препараты кальция. В лечение гипоталамического синдрома включают рефлексотерапию, физиопроцедуры, лечебную гимнастику. В структуре лечения гипоталамического синдрома важная роль отводится нормализации режима отдыха и работы, диете, нормализации массы тела, курортотерапии.
Прогноз и профилактика гипоталамического синдрома
Гипоталамический синдром может приводить к снижению и утрате работоспособности в случаях часто повторяющихся вегетативных пароксизмов. Таким пациентам с учетом их профессиональной деятельности может устанавливаться инвалидность III группы. Резко выраженные нейроэндокринно-обменные формы гипоталамического синдрома также могут приводить к потере трудоспособности с установлением III или II группы инвалидности.
Поскольку кризы при гипоталамическом синдроме, как правило, возникают в определенное время и при изменениях метеоусловий, значительных эмоциональных и физических перенапряжениях, их профилактика заключается в предупреждающем приеме седативных средств, антидепрессантов, транквилизаторов. Также, по возможности, необходимо исключить провоцирующие приступы факторы, нервно-психические и физические нагрузки, работу в ночные смены.
Читайте также:
